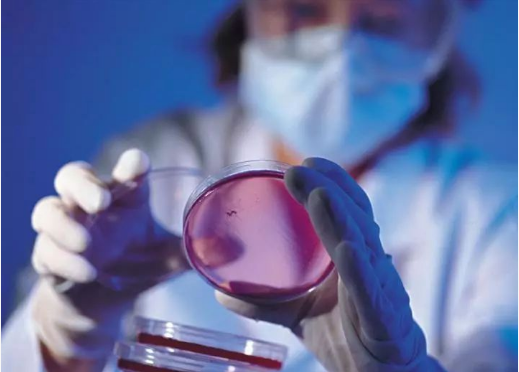
4.png

稀土永磁
稀土永磁材料是将钐、钕混合稀土金属与过渡金属(如钴、铁等)组成的合金,用粉末冶金方法压型烧结,经磁场充磁后制得的一种磁性材料。

稀土永磁材料是现在已知的综合性能最高的一种永磁材料,它比九十世纪使用的磁钢的磁性能高100多倍,比铁氧体、铝镍钴性能优越得多,比昂贵的铂钴合金的磁性能还高一倍。由于稀土永磁材料的使用,不仅促进了永磁器件向小型化发展,提高了产品的性能,而且促使某些特殊器件的产生,所以稀土永磁材料一出现,立即引起全国的极大重视,发展极为迅速。我国研制生产的各种稀土永磁材材料的性能已接近或达到国际先进水平。
随着科技的进步,稀土永磁材料不仅应用计算机、汽车、仪器、仪表、家用电器、石油化工、医疗保健、航空航天等行业中的各种微特电机,以及核磁共振设备、电器件、磁分离设备、磁力机械、磁疗器械等需产生强间隙磁场的元器件中,而且风力发电、新能源汽车、变频家电、节能电梯、节能石油抽油机等新兴领域对高端稀土永磁材料的需求日益增长,应用市场空间巨大。
在应用稀土的各个领域中,稀土永磁材料是发展速度最快的一个。它不仅给稀土产业的发展带来了巨大的推动力,也对许多相关产业产生相当深远的影响。
能“揩”海洋油污“大绒布”
2018年年初,载有11.13万吨凝析油的巴拿马籍油船“桑吉”轮与中国香港籍散货船“长峰水晶”轮相撞,导致“桑吉”轮全船失火爆燃,船上所载凝析油及燃料油大量泄漏,对沉船周边海域生态环境造成极大威胁。

此时,一种树脂型高分子聚合物吸油材料“临危受命”,用它制成的鱼鳞型吸油拖栏被固定在船只上对污染海域进行拦截,凭借其高吸附效能与快速的吸附能力迅速应对油污扩散,最短时间内便“吞”光油污。
该材料是吸附—催化降解耦合新材料,俗称“吸油宝”,其外形酷似海绵样的白色绒布,看起来并无特别之处。然而,正是这看似极为平常的“白色绒布”,已是油污治理的一大“法宝”,此前就参与过韩国“鑫川8号”货轮撞桥燃油泄漏、大连原油泄漏等国内外40多起突发性事故的应急处置,尤其在美国墨西哥湾原油泄漏处置中效果突出,美方称“验证了吸油宝的神奇”。
其实,“吸油宝”从无到有,再到实际应用,可谓是“过关斩将”。早在上世纪六七十年代,美国和日本的科学家就基本判定吸油树脂的吸油机理是基于范德华力,其吸油速度不可能快于4-6小时。
“权威”结论并没有让研究人员“止步”,研究人员先后针对数十种典型油类所含成分设计合成了近千种不同分子结构的单体和聚合物,再从中筛选出近百种吸附性能优异的单体进行组合,其间还不断检测聚合物对不同油品的吸附性能。经过数千次的实验摸索,解决了产品吸油后锁油能力低下、强度差等缺陷,并一举推翻国外结论,让吸油树脂产品从几个小时的饱和吸附时间大大缩短到令人难以置信的“11秒以内”,突破了世界性难题。
产品研发成功了,随之而来的问题便是如何让其投入应用,找到真正的“用武之地”。由于吸油树脂产品呈颗粒状,无法直接用于大面积水面浮油的清理,因而需要通过技术改造,将颗粒状的吸油树脂变成一种可漂浮于水面,并且能和机械装备联动配套使用的海绵状轻质吸油材料,也就是由“点”及“线”,再编织成“面”。功夫不负有心人,研究团队成功研制了材料成纤化装备和编织装备,实现了海绵状吸附材料工业化量产。
更为难得的是,“吸油宝”对于淤泥的处理也是“手到擒来”。由于淤泥中含有大量束缚水,使其难以焚烧造成污染。而将“吸油宝”铺在淤泥上,数秒内便能将淤泥中的大部分水吸收掉,便可直接焚烧淤泥。“吸油宝”迅速被投放到企业,在陕西延长油田、中石油克拉玛依油田等多地建立油水分离中心处理站,并且在河道治理、印染、农药、化工、喷涂等行业建立起数十个废气和废水处置工程,极大地降低了企业污染治理的成本负担,取得了良好的经济效益和巨大的社会环境效益。
能够自我润滑的材料
即使你被蚯蚓恶心到了、尽管它们生活在泥土里,但不可否认的是这些生物通常都很干净。这是因为它们会不停地分泌一种润滑黏液,这样污垢就无法附着在上面。现在,有科学家利用蚯蚓的这种特性打造了一种新材料,它将能找到许多用途。

来自德国莱布尼茨新材料研究所的一个科研团队研发出了一种表面有微小孔洞并含有硅油液滴的橡胶聚合物。
通常情况下,硅油停留在聚合物里面。但当对它施加压力之后,液滴就会改变形状,它们会从小孔洞中渗出到材料表面。之后,它们就形成了一个润滑层,当与周围环境发生摩擦时,这种润滑层就会不断地得到硅油补充。
有趣的是,聚合物的表面并非光滑而是粗糙的,这实际上能够起到增加润滑的作用,因为它可以使油更好地附着在聚合物表面。经过对光滑表面聚合物和粗糙表面聚合物的对比测试发现,粗糙表面的油馍大概能维持1万次的摩擦,而光滑的则只能维持3000次。
可以想象,这种材料可以在任何物体需要滑过或穿过固体结构的情况下使用,另外它还可能具有生物医学用途,因为在其表面生长的微生物会不断脱落。
新材料只用光和二氧化碳即可生长
科研人员即将推出可“自我修复”的材料。一旦面市,很可能作为自我修复涂料得到广泛应用,比如用于汽车修理、手机和织物。当表面裂开或划伤时,它可通过接触空气和阳光填补裂缝,无需采取其他措施。此外,这种材料运输成本低、能耗少,因为能够以轻小型尺寸运抵制造商和建造商。到达目的地后再暴露在空气和阳光中,它就会膨胀、固化和硬化。
研究人员说,这种材料不仅可避免使用化石燃料,而且还可吸收空气中的二氧化碳,这显然有利于环境和气候。
麻省理工学院化学工程教授说:“我们人类可以选择,要么从地下开采石油建设世界,制造我们随处可见的塑料,要么遵循自然使用空气中的碳。第一步是设想可以像植物和树木一样生长和自我修复的材料,下一步就是付诸实践。然后,经过改良和优化,我们就能用这些可以不断更新的新型材料代替现在会腐烂的材料了。”
这种产品的美妙之处就在于“它除了空气中的二氧化碳和环境光之外什么都不需要,而这两样东西无处不在。这些材料吸收空气中的碳物质,不断地自我修复,而且无需任何外部刺激。以二氧化碳和外界光构建的材料使用的能源是我们今天唾手可得的。这是回归最基本定义的可持续发展”。
斯特拉诺的实验室最近创造出一种材料——可与空气中的二氧化碳进行化学反应,继而生长、固化甚至实现自我修复。科研人员说,与材料领域其他研究不同的是,他们研究的这种材料无需外部输入任何能量,比如热能、紫外线、化学品或机械应力。研究的结果就是一种胶状合成聚合物,并利用了科研人员从菠菜叶子中提取的叶绿体(即植物进行光合作用的生物成分)。这种聚合物不断把二氧化碳转化成自我强化的碳基物质。
纳米材料nanocardboard问世
每个人都熟悉纸板,这种纸制品通常用于制作各种各样的纸盒。纸板的问题在于,虽然它重量轻且具有相当的强度,但该材料不适合多种用途。对于需要更高强度和耐用性的用途,研究团队创建了一种名为nanocardboard的新材料。

Nanocardboard这种材料由氧化铝薄膜制成,厚度为几十纳米。该材料形成一个高度为几十微米的中空板,是一种类似于瓦楞纸板的夹层结构,这是Nanocardboard名称的来源。根据项目工程师的说法,夹层结构的硬度是相同质量实心板的一万倍。
对于一块平方厘米大小的材料,这种非常轻质的材料可以使专重量下降到千分之一克以下。尽管其重量轻且设计薄,但材料具有弹性,并且在弯曲成两半后可以弹回其原始形状。该材料的刚度和重量比使其成为航空航天和微机械应用的理想选择。
除了轻薄外,Nanocardboard的机械性能使其成为优良的绝热体。从事该项目计划的工程师将探索纳米碳材料中发现的现象,当光照射在Nanocardboard上时,材料可以漂浮。当材料每侧的表面温度不同时,悬浮发生,并且空气分子气流通过Nanocardboard的底部流出。
上面显微镜下的Nanocardboard图像显示了材料的独特篮子编织图案。这种图案赋予材料一些强度并使其抵抗皱纹,并且是抗弯曲性的关键。 Nanocardboard可以弯曲并恢复,好像弯曲从未发生过一样。
更多关于材料方面、材料腐蚀控制、材料科普等方面的国内外最新动态,我们网站会不断更新。希望大家一直关注中国腐蚀与防护网http://www.ecorr.org
责任编辑:殷鹏飞
《中国腐蚀与防护网电子期刊》征订启事
投稿联系:编辑部
电话:010-62313558-806
邮箱:fsfhzy666@163.com
中国腐蚀与防护网官方 QQ群:140808414
免责声明:本网站所转载的文字、图片与视频资料版权归原创作者所有,如果涉及侵权,请第一时间联系本网删除。
官方微信
《腐蚀与防护网电子期刊》征订启事
- 投稿联系:编辑部
- 电话:010-62316606
- 邮箱:fsfhzy666@163.com
- 腐蚀与防护网官方QQ群:140808415



